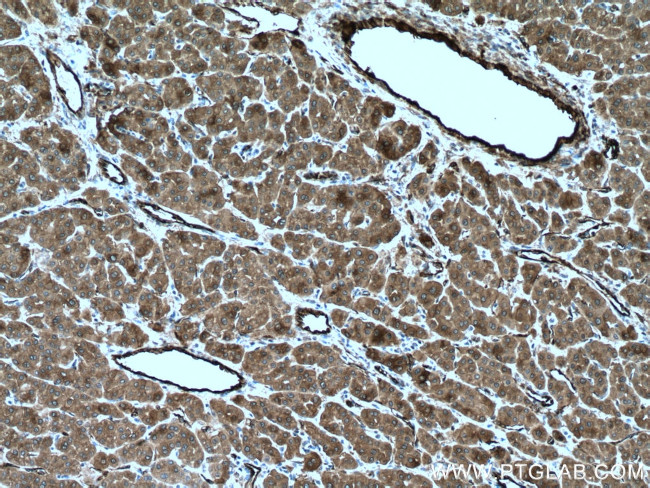
TGM2 Antibody in Immunohistochemistry (Paraffin) (IHC (P))

Search
Proteintech
TGM2 Polyclonal Antibody
{{$productOrderCtrl.translations['antibody.pdp.commerceCard.promotion.promotions']}}
{{$productOrderCtrl.translations['antibody.pdp.commerceCard.promotion.viewpromo']}}
{{$productOrderCtrl.translations['antibody.pdp.commerceCard.promotion.promocode']}}: {{promo.promoCode}} {{promo.promoTitle}} {{promo.promoDescription}}. {{$productOrderCtrl.translations['antibody.pdp.commerceCard.promotion.learnmore']}}
产品信息
15100-1-AP
种属反应
已发表种属
宿主/亚型
分类
类型
抗原
偶联物
形式
浓度
规格
纯化类型
保存液
内含物
保存条件
运输条件
产品详细信息
Immunogen sequence: MAEELVLER CDLELETNGR DHHTADLCRE KLVVRRGQPF WLTLHFEGRN YEASVDSLTF SVVTGPAPSQ EAGTKARFPL RDAVEEGDWT ATVVDQQDCT LSLQLTTPAN APIGLYRLSL EASTGYQGSS FVLGHFILLF NAWCPADAVY LDSEEERQEY VLTQQGFIYQ GSAKFIKNIP WNFGQFEDGI LDICLILLDV NPKFLKNAGR DCSRRSSPVY VGRVVSGMVN CNDDQGVLLG RWDNNYGDGV SPMSWIGSVD ILRRWKNHGC QRVKYGQCWV FAAVACTVLR CLGIPTRVVT NYNSAHDQNS NLLIEYFRNE FGEIQGDKSE MIWNFHCWVE SWMTRPDLQP (1-349 aa encoded by BC003551)
靶标信息
Transglutaminase (TGase) catalyses the crosslink of proteins by forming e-(g-glutamyl) lysine isopeptide bonds and requires the binding of Ca2+ for its activity. In mammals, eight distinct TGase isoenzymes have been identified. Tissue transglutaminase (tTGase), also known as TGase 2, has four distinct domains: N-terminal b-sandwich, catalytic core and two C-terminal b-barrel domains. tTGase may have a role in cell death, cell proliferation, cell differentiation, and receptor-mediated endocytosis. In the Alzheimer's disease brain, the elevated tTGase activity is manifested by polymerization of a number of proteins, including Ab peptide, b-amyloid precursor protein and the tau protein, with formation of neurofibrillary tangles.
仅用于科研。不用于诊断过程。未经明确授权不得转售。
生物信息学
蛋白别名: C polypeptide; C polypeptide, protein-glutamine-gamma-glutamyltransferase; crosslinker; Erythrocyte transglutaminase; G alpha h; G(h); G-ALPHA-h; GNAH; Heart G alpha(h); hhG alpha(h); Isopeptidase TGM2; Protein G alpha(h); Protein G(h); Protein-glutamine deamidase TGM2; Protein-glutamine dopaminyltransferase TGM2; Protein-glutamine gamma-glutamyltransferase 2; Protein-glutamine histaminyltransferase TGM2; Protein-glutamine noradrenalinyltransferase TGM2; Protein-glutamine serotonyltransferase TGM2; protein-glutamine-gamma-glutamyltransferase; RP5-1054A22.2; TG C; TG(C); TG2; TGase 2; TGase C; TGase H; TGase II; TGase-2; TGase-H; TGC; Tissue transglutaminase; Tissue type transglutaminase; tissue-type transglutaminase; Transglutaminase 2 C polypeptide; transglutaminase 2, C polypeptide; Transglutaminase C; Transglutaminase H; Transglutaminase II; Transglutaminase-2; tTG; tTgase; unnamed protein product
基因别名: G(h); G[a]h; hTG2; TG(C); TG2; TGase2; TgaseII; TGC; TGM2; tTG; tTGas
UniProt ID: (Human) P21980, (Rat) Q9WVJ6, (Mouse) P21981
Entrez Gene ID: (Human) 7052, (Rat) 56083, (Mouse) 21817